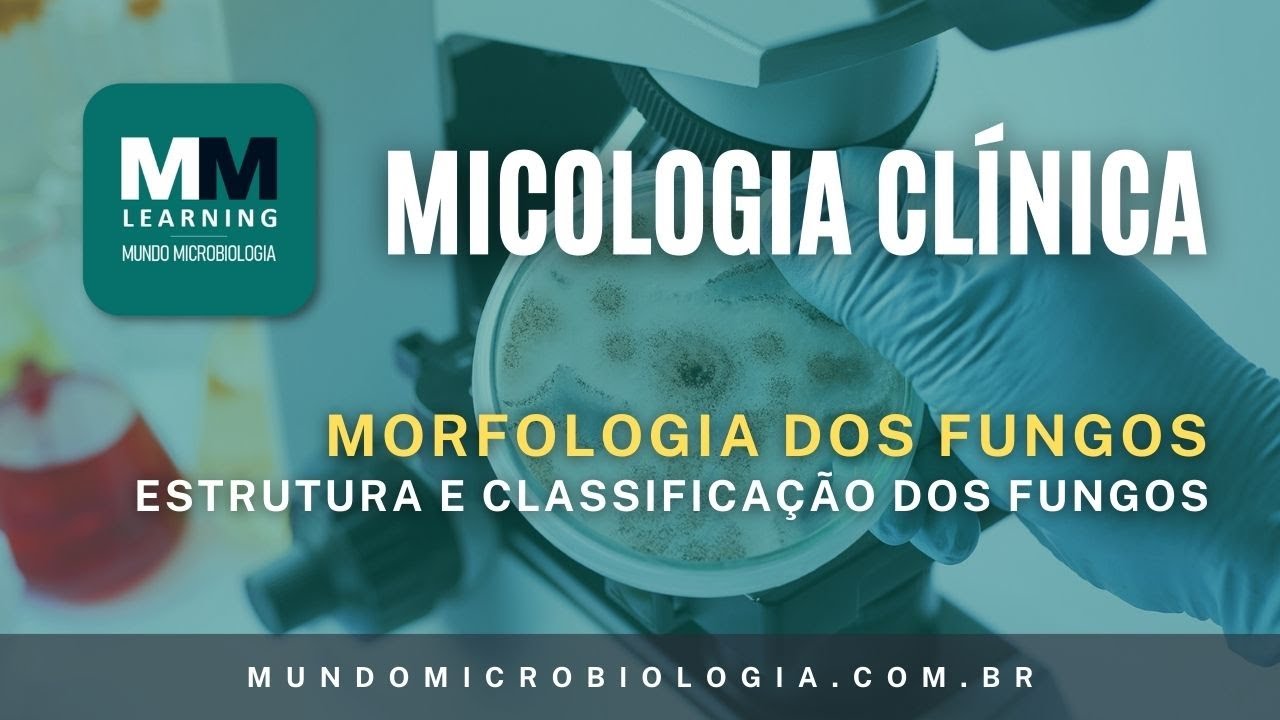
Estrutura e Classificação dos Fungos - Micologia Clínica

é o maior organismo vivo do planeta terra é um fungo da espécie armillaria ostoyae ele vive próximo ao monte adams no estado de washington nos estados unidos e ocupa uma área de seis milhões de metros quadrados eu e joão guilherme eu sou professor de biologia e te convido vem comigo é [Música] ó nessa primeira aula sobre fungos a gente vai entender quem são os representantes do grupo nós vamos caracterizar o grupo enfim e abordar também a sua estrutura celular como que essa célula é e como ela se organiza vamos lá quem que são os fungos
quem que pertence ao reino fungi cogumelos bolores mofos orelhas-de-pau e leveduras é importante lembrar das leveduras porque elas são os organismos unicelulares dentro do reino fungi normalmente a gente lembra aos fungos são seres pluricelulares cuidado existe um representante unicelular as leveduras quais são as características mais importantes primeiro são seres eucariontes até então gente tava estudando seres procariontes né as bactérias seres que não têm núcleo individualizado com uma carioteca uma membrana nuclear agora não os fungos têm todos seu material genético internalizado dentro de uma estrutura de membrana nuclear o que permite dizer que sim são eucariontes
não temos representantes unicelulares como eu comentei as leveduras e pluricelulares com detalhe nenhum fungo forma tecidos eles têm organização das suas células mas não existe uma função atribuída de maneira diferente a essas células a ponto de caracterizar tecidos então não existem células que em conjunto realizam revestimento nem preenchimento da em condução nem nada parecido todas as células são mais ou menos iguais por isso não formam tecidos outra coisa importante por mais que alguns fungos às vezes tem uma tonalidade mais esverdeada a gente não pode esquecer que todos sem exceção todos os fungos são seres heterótrofos
nenhum tem capacidade de fazer fotossíntese ou quimiossíntese nenhum deles produzem o seu próprio alimento são seres que em sua maioria são decompositores depois a gente vai estudar existem também fungos causadores de doenças parasitas no entanto o que são muito a lista se associam por exemplo com algas e forma estruturas denominadas de lins mas isso a gente vai ver no futuro uma coisa importante a respeito de fungos que às vezes passa batido nas suas células existem paredes celulares a parede celular de um fungo não é formado de celulose como a gente encontra lá no vegetal é
formado de um carboidrato nitrogenado chamada de quitina lembra que essa quintina também está presente em animais formando um exoesqueleto de seres denominados de artrópodes na sequência lembra também que de maneira similar aos animais os fungos têm reserva nutritiva na forma de glicogênio você e eu que somos mamíferos também fazemos reserva de gordura mas antes da gordura ser processada quando você precisa ativar as suas reservas você vai se utilizar de glicogênio o glicogênio nada mais é do que um encadeamento bem gigantesco de 15 mil 30 mil moléculas de glicose esse glicogênio fica normalmente guardado no fim
o ou na sua musculatura esquelética no caso dos fungos dentro de suas células células essas que nós vamos chamar de hifas tome cuidado anote isso a célula de um fungo recebe um nome especial ela não é simplesmente célula ela se chama hifa toda vez que você vê se nome hifa você tem que lembrar ou para a gente está tratando aqui especificamente de um fungo o que que é interessante essas células não formam tecidos mas o conjunto de hifas ou seja de células fúngicas vai formar um micélio então observe ou conjunto de hifas que nada mais
são do que as células fúngicas que guardam glicogênio como substância de reserva assim como os animais que tem parede celular assim como os vegetais mais feita de quitina como os artrópodes que são animais também beleza a célula é a iva que forma o micélio agora não dá uma olhada como que está estruturado esse mistério como tu vem aqui que nós temos fungos diferentes abra os olhos estão só arrancar esse cogumelo e te entregar isso aí é um fungo isso não é um fungo você é parte de um fungo a gente acha que o cogumelo é
o fundo esse mas o cogumelo nada mais é do que estrutura reprodutiva de um fungo tanto que se você tiver passeando pelo mato lá tiver um tronco como esse aqui e nesse tronco tiver um cogumelo e você arrancar esse cogumelo se ele tiver maduro você tá ajudando fungo você tá dispersando os esporos desse fungo por aí claro que você se cogumelo de velho imaturo os esporos não vão ser dispersos mas no momento que você espalha os esporos olha eles estão saindo aqui pelo vendo você tá ajudando o fundo e você não tá matando o forro
que o fundo de verdade tá dentro do tronco então importante a gente saber essa estrutura que no caso é um cogumelo existem outros tipos de fungos claro a gente vai chamar na biologia de corpo de frutificação só que esse nome ele tá entrando em desuso os unicologista som o estudo fungos os caras que vão passar a dedicar a sua vida em cima de estudos de fungos não gostam nessa expressão frutificação porque purificação nos remete a fruto nos remete a planta e fungo não é planta muito embora historicamente a gente achou por muito tempo que os
fungos eram plantas ele sempre são estudados dentro das disciplinas e botânica os fungos não são plantas então o termo correto para esse negócio você tá vendo chamado de cogumelo é um e célio o micélio reprodutivo quando eu tiro esse mistério a mesma coisa que eu tô tirando uma laranja no pé eu tô tirando a estrutura reprodutiva tá matando o pé de laranja você tá tirando uma laranja você pode até ajudar essa laranja se expressar largando a semente dela por aí você pode até ajudar o fungo se dispersar lá e manda os seus esporos por aí
aonde tá o fungo de verdade dentro do tronco formando aquilo que a gente chama de micélio também mas o micélio vegetativo mistério que permite o funcionamento vital daqueles e é esse mistério que a gente vai analisar por aqui olha só eu peguei um pedaço do ministério um conjunto de células aqui e vamos observar mais de perto eu dei um zoom ela aqui ó você tem uma célula aqui outra célula aqui outra célula aqui outra aqui eu tô aqui eu tô aqui o que que a gente consegue perceber entre uma célula e outra existe uma barreira
não completa de parede celular ela quase se toca não em troca por inteiro essa estrutura a gente chama de septo o septo dá uma individualidade fisiológica para célula então cada célula zinha funciona de quase que de maneira independente claro que eu precisa do social os vizinhos mas ela tem autonomia funcional porque ela é sepultada existe uma célula aqui em um certo separando ela de outra célula o que está aqui embaixo muito bem os cogumelos são exemplos de fungos com hifas septadas e era isso que eu queria que você lembrasse existem outros fungos por exemplo um
fungo que tá nascendo é todo um bichinho que podem não ter os septos olha como que são essas ninfas aqui ó isso aqui é uma célula outra célula outra outra outra outra outra mas não existe uma barreira física entre uma célula e outra existe um conte no 12v esse tipo de fundo tem uma capacidade de crescimento absurdamente grande porque porque o crescimento dele é continuar troca de substâncias do material citoplasmático é completamente livre porque não existe barreiras claro um fungo mais sensível porque uma substância tóxica aqui entre em contato com uma célula pode se esparramar
rapidamente para todas as outras células mas a fisiologia nesse seria acelerada ele cresce muito rapidamente esse fungo e não tem certos como você está podendo ver a gente chama de fungos cenocíticos ou com hifas cenocíticas a mesma coisa seria dizer não septado ok sem os septos lembrando que isso aqui em amarelo são as paredes celulares e essas bolinhas aqui são os núcleos celular o dono fungos e pintado quanto não sentado ok a nossa próxima aula eu quero dar exemplos de grupos de fungos e também tratar da reprodução em cada um deles fica aí que eu
tenho um recado final para você eu espero sinceramente que você esteja gostando os as nossas aulas e lembre-se essa aula que você acabou de assistir não é algo isolado dentro do canal ela faz parte de uma sequência aqui no módulo 4 e não esqueça também que existem outros módulos 1 2 ou 3 5 6 7 e 8 toda a biologia do ensino médio está disposta para você de maneira gratuita que você apoia esse tipo de projeto e inscreva-se no canal dê um like nesse vídeo e compartilha essas aulas como seus amigos é muito importante para
nós ok e um outro recado que eu preciso dar para você dentro em breve a gente estará inaugurando a biológia lá você vai poder encontrar mapas mentais resumos e apostilas especiais para os principais vestibulares do brasil enem aguarde biológia é bem namorada um link aqui na descrição estará